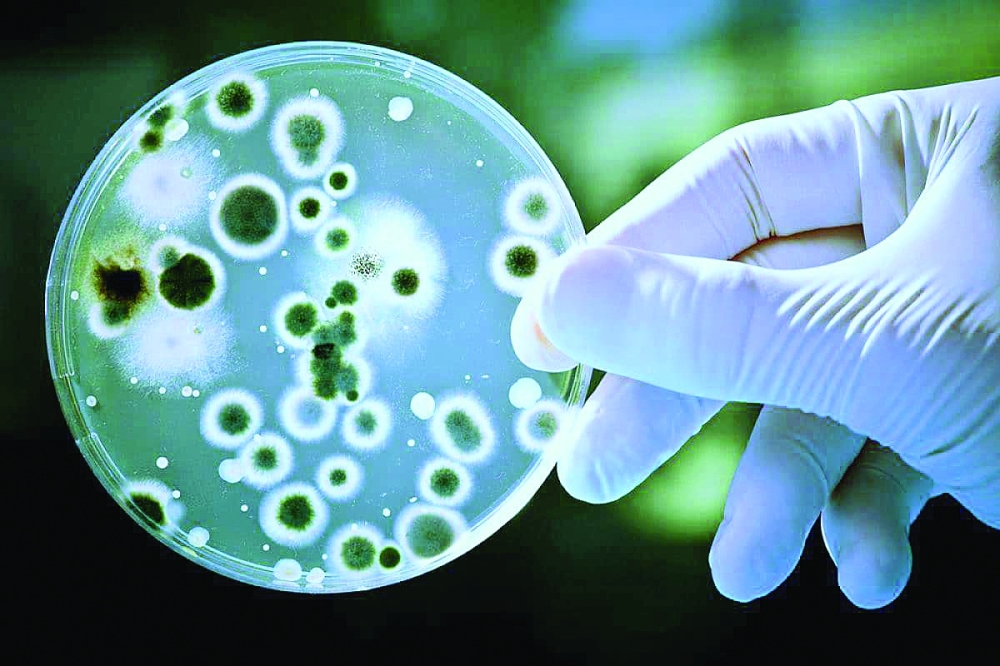
No Image

"مورد" يستشرف مستقبل الصناعة الحيوية في سلطنة عمان
د. عبدالله الحاتمي:
ـ العمل على فطريات من البيئة العمانية لإيجاد مضادات حيوية ومركبات كيميائية
عبدالله الشحي:
ـ يمكن استخدام الفطريات في استصلاح الأراضي الزراعية ومكافحة الملوحة
نظم المقهى العلمي التابع لمركز عُمان للموارد الوراثية الحيوانية والنباتية "مورد" بوزارة التعليم العالي والبحث العلمي والابتكار الجلسة العلمية الرابعة ضمن الموسم العلمي للمقهى، وذلك بعنوان (قضايا عميقة في مخلوقات دقيقة: علم الأحياء الدقيقة الصناعي ومستقبل الصناعات الحيوية) استضاف خلالها الدكتور عبدالله بن محمد الحاتمي أستاذ مساعد ومسؤول مختبر الأحياء الدقيقة بمركز أبحاث العلوم الطبيعية والطبية من جامعة نزوى، والمهندس عبدالله بن محمد الشحي متخصص زراعي ومؤسس ومدير مؤسسة أركان للبحث والتطوير والابتكار.
وقال الدكتور عبدالله الحاتمي: إن الأحياء الدقيقة تنقسم إلى عدة أقسام بينها البكتيريا والفطريات والفيروسات والطفيليات والطحالب وغيرها، وسميت دقيقة كونها لا ترى بالعين المجردة ولها استخدامات عديدة جداً.
وأشار إلى أن التقنيات الحيوية والأحياء الدقيقة تعد مصدرا لصناعة الأدوية، إذ معظم المضادات الحيوية تنتج من كائنات حية دقيقة سواء الفطريات أو البكتيريا، كما تدخل الكائنات الدقيقة في صناعة الأغذية كالأجبان والخبز وغيرها بالإضافة إلى ذلك تدخل أيضاً في صناعة الأسمدة وكذلك تحليل التربة التي تنتج النيتروجين الذي يساعد على نمو النباتات، وتدخل كذلك في عالم الطب على سبيل المثال هرمون الأنسولين يصنع باستخدام أنواع من الكائنات الحية الدقيقة، إذ أن هناك عدة صناعات قائمة حالياً، مشيراً إلى أن إمكانية الاستفادة من الدول المتقدمة في علم الأحياء الصناعي، وعلى سبيل المثال نحن نستورد البكتيريا والفطريات المستخدمة في صناعة الطحين ومن السهل تحضيرها وإنتاجها محلياً وكذلك المضادات الحيوية بالإمكان إنتاجها وتعبئتها في سلطنة عمان، متى ما توفرت الإمكانيات والخبراء والبحوث.
وأضاف: إن الكائنات الحية الدقيقة في البيئة العمانية لم تدرس دراسة مستفيضة، وأذكر أن البروفيسور عبدالله السعدي بكلية العلوم البحرية والزراعية بجامعة السلطان قابوس بدأ أبحاثه على الفطريات وقام بجمع أعداد كبيرة منها وقدم هذا المشروع بالتعاون مع مركز عمان للموارد الوراثية الحيوانية والنباتية، وبعد فترة كان ثمة تعاون مع جامعة نزوى وتم تخزين هذه الفطريات، ومن خلال أبحاث البروفيسور عبدالله السعدي تم اكتشاف عدد كبير من الفطريات وتم تسجيلها باسم سلطنة عمان.. مضيفاً: تركيزي كان على الفطريات الطبية، والعام المنصرم تلقينا حالة مريض من مستشفى جامعة السلطان قابوس لديه نوع من الفطر لم يسجل سابقا على مستوى العالم، وتم تسجيل هذا الاكتشاف الجديد ونشره بأسماء الباحثين والعلماء المشاركين، وميزة هذا الفطر أنه وجد فقط في سلطنة عمان وهو فطر قاتل، إذ تم اكتشافه لدى 4 مرضى، اثنين توفيا وتم علاج الاثنين الآخرين، والعمل جارٍ لمعرفة العلاقة بين الوزغ والفطر القاتل.
تعايش الكائنات
وأكد أن جامعة نزوى بدأت عبر فريق البروفيسور أحمد الحراصي عزل مجموعة من الفطريات من البيئة العمانية ويعمل حالياً على عزل المكونات الكيميائية لهذه الفطريات لإيجاد مضاد حيوي أو مركب كيميائي مفيد، والأبحاث في هذا الجانب قائمة بجامعة نزوى.
وأوضح أن الكائنات الحية الدقيقة تعيش في بيئات مختلفة، ولكل دولة ميزة مختلفة عن غيرها إذ أن السلطنة تتميز بطقسها الحار والجاف وتعيش فيها فطريات وبكتيريا تتواءم مع هذا الطقس، وهناك توزع جغرافي للكائنات الحية الدقيقة وأكثر من هذا أن الكائنات الحية الدقيقة تعيش في أعماق البحار كالشعاب المرجانية.. موضحاً: أن حفظ الكائنات الدقيقة الحية يختلف بعضها عن بعض.
سد الفجوة البحثية
من جهته قال المهندس عبدالله الشحي مدير مؤسسة أركان للبحث والتطوير والابتكار: توجهات المؤسسة سد الفجوة البحثية في سلطنة عمان وعرضها على المستثمرين، ومعالجة التحديات التي تواجه المزارعين وترتبط بعلاقات وثيقة مع جامعة السلطان قابوس ومركز عمان للموارد الوراثية الحيوانية والنباتية وجامعة نزوى كقطاعات أكاديمية بحثية بالإضافة إلى وزارة الثروة الزراعية والسمكية وموارد المياه، ونعمل بحسب الإمكانيات المتاحة والمتوفرة.
أضاف: اهتمامنا بالأحياء الدقيقة كون اتجاه العالم يتجه إلى الصناعات العضوية واستخدام الكائنات الدقيقة، مشيراً إلى أن سلطنة عمان زاخرة بأنواع مختلفة من الكائنات الحية الدقيقة والتي ببساطة يمكن الحصول عليها.
وأضاف: تقوم الكائنات الحية الدقيقة على تنظيف التربة بشكل دوري وكل كائن دقيق هو مصنع بحد ذاته، وقد أثبتت دراسة للبروفيسور سيف البحري أن هناك بكتيريا في مناطق الامتياز تعيش على المواقع الملوثة بالمنتجات النفطية وذات الملوحة العالية، وهذا الاكتشاف ربما يقودنا إلى استصلاح أراضينا لمناطق محافظتي الباطنة التي تأثرت تأثراً كبيراً بالملوحة والاستخدام المفرط للمواد الكيماوية، والآن الفطريات والبكتيريا تتحكم في استصلاح الأراضي الزراعية وتساعد النباتات، وأهمية الكائنات الدقيقة ليس فقط في القطاع الزراعي، ويعد السيليكون العنصر المنسي في القطاع الزراعي.. مضيفاً: يمكن للسلطنة الاستفادة من الكائنات الدقيقة في قطاعات عدة كالتعدين والزراعة، حيث إن هذين القطاعين واعدين، بالإضافة إلى إعادة أقلمت التربة بسبب التلوثات سواء أكانت نفطية أو زراعية وكذلك الاستخدامات الطبية والتجميلية وكلها مطبقة في العديد من الدول بالعالم.
شراكة مؤسسية
وقال الشحي: حان الوقت لتضافر الجهود الحكومية والقطاع الخاص للتنقيب عن مواردنا الوراثية الدقيقة واستغلالها الاستغلال الأمثل، مؤكداً بدء مؤسسة أركان للبحث والتطوير والابتكار بالعمل على مشروع بحثي تجريبي استثماري للتنقيب عن بعض الكائنات الحية الدقيقة بالشراكة مع مركز عُمان للموارد الوراثية الحيوانية والنباتية، والهدف من المشروع أنه خلال 3 سنوات سوف نحصل على كائنات دقيقة من الممكن استثمارها في القطاع الصناعي.